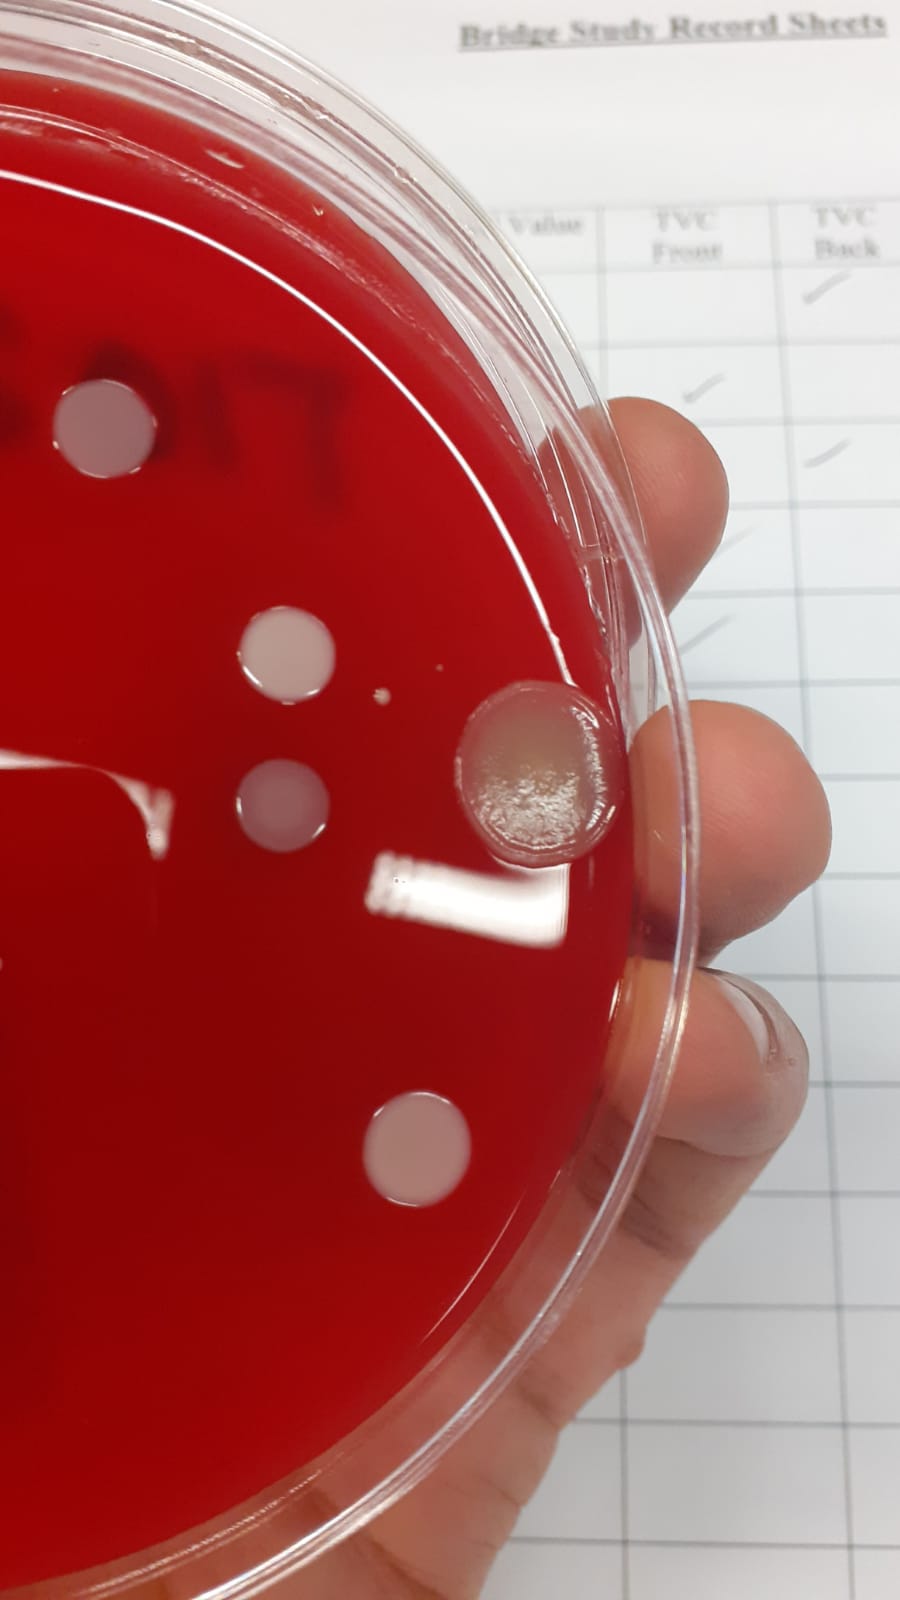

Your Starter for 10: Antimicrobials
After my sojourn in my Ivory Tower on Friday, I wanted to get back to posting about antibiotics this week. Although I only really intend to post once a week, I thought it might be useful, if I’m going to be posting about antimicrobial resistance (AMR), to post a little bit about what an antimicrobial … Continue reading Your Starter for 10: Antimicrobials
8 Comments